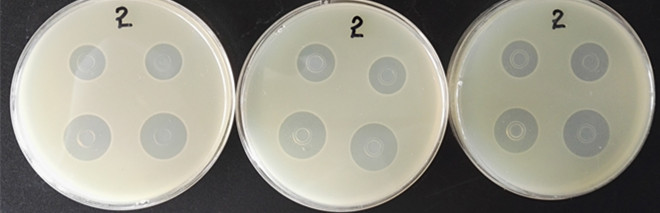

海博微信公众号
海博微信公众号
 海博天猫旗舰店
海博天猫旗舰店


 海博微信公众号
海博微信公众号
 海博天猫旗舰店
海博天猫旗舰店




管碟法是国内外常用的抗生素微生物检定法,利用管碟法测定抗生素效价,具有准确、直观、重复性好等优点,因而被广泛采用。但是整个试验过程中影响结果的因素很多,任何一个环节操作不当或者忽略就会造成很大误差,导致整组试验失败。其中,芽孢悬液的制备就有很多需要注意的地方。
在用管碟法检定抗生素时,需要将菌悬液与培养基混合均匀、覆盖在底层培养基上,以形成抑菌圈。其中,对于菌悬液的制备要求为:
将所用菌的斜面培养物用1~2ml灭菌水洗下,形成菌悬液;将菌悬液在营养琼脂平皿上均匀涂布,置于35-37℃条件下培养7天;涂片、染色,镜检芽孢率≥85%时,用10ml灭菌水将芽孢和菌体的混合物洗下,制成悬液;65℃水浴加热30min,杀死菌体,形成有活性的芽孢悬液;冷却、冰箱中保存备用。
根据实际操作中的经验,对这一环节需要注意的事项总结如下:
1 应该严格按照标准操作,将涂好的平皿连续培养7天再洗脱芽孢,这样也有助于芽孢悬液的均一性,避免由于操作标准不一造成的试验结果的偏差。有文章报道,将平板培养至2、3、4、5、6天与培养至第七天,制成的悬液在抗生素效价测定中无差异;但本人在实际试验中发现,培养3天的短小芽孢菌,镜检时芽孢率<80%,并且平皿一旦从培养箱中拿出来,室温放置至第10天,芽孢率也不会再发生明显变化,这显然不符合《中国兽药典》规定的芽孢率≥85%的要求。
2试验菌的菌龄对抑菌圈有一定影响。故检定时应保持菌种及菌液的新鲜。一般菌种一月转种一次,冰箱冷藏保存。对易变异的菌株,如藤黄微球菌等在制备菌悬液前进行单菌分离;其他菌株可半年分离一次。
3 试验菌传代最好不超过5次,以防止菌种老化变异。芽孢杆菌培养物用灭菌水洗下后,应在65℃加热30分钟,使菌体的菌龄一致(有资料显示可70-75℃水浴30min杀死菌体)。
4 加入菌悬液的体积,一般不少于0.3ml,并且不大于上层培养基体积的1%(有资料说不大于2%)。如果加入菌悬液的体积过小,则在同次实验中,不同次加入菌悬液的体积相差较大, 造成实验误差;如果加入菌悬液的体积过大,则会使上层培养基变稀,并且因菌悬液的温度较低,加至培养基中可能造成培养基结块,影响测定结果。对于加入菌悬液体积的控制,可通过调节菌悬液的浓度来实现。
下面为在海博生物技术公司生产的抗生素检定Ⅳ号琼脂上,莫能菌素对短小芽孢菌的抑菌效果:
图a 连续培养7天的短小芽孢菌

图b 莫能菌素对短小芽孢菌的抑菌效果
从照片可以看出,菌悬液中芽孢率符合要求(≥85%),抑菌圈透明、边缘清晰且直径均匀,符合标准规定的18-22mm,效果非常好!
注:本文属海博生物原创,未经允许不得转载。
上一篇:LST培养基灭菌失败的原因分析
下一篇:支原体简介和常见问题



